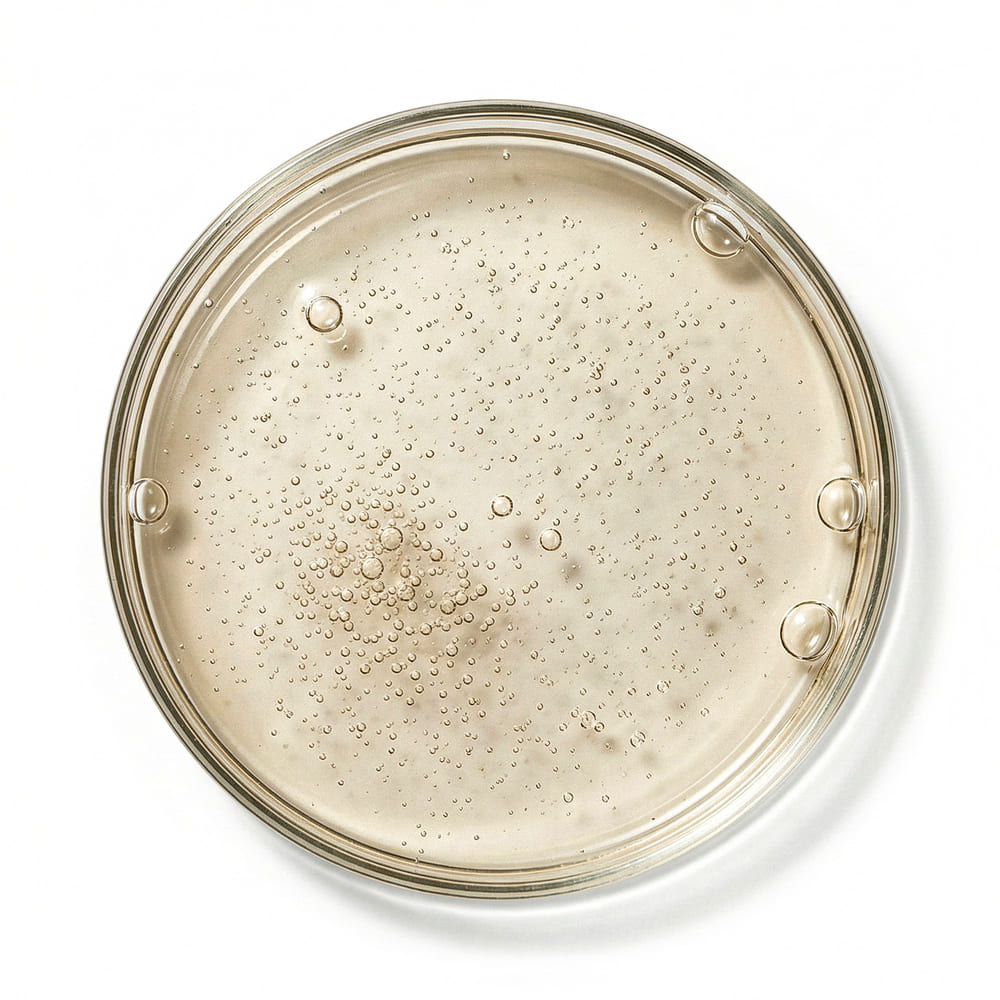

-
What is lactic acid?A mild exfoliating acid (AHA) found naturally in skin and milk sugars.
-
Is it safe for sensitive skin?Yes, in low, well-formulated levels. Start slowly if you’re very sensitive.
-
Will it sting ?It can. Wait until skin feels calm, and don’t apply on broken skin.







Maximize your antiperspirant’s power with our Boosting DeepWash. Infused with PureFoam+ concentrate. It deeply cleanses and exfoliates your skin.
-
 Boosts Antiperspirant Effect
Boosts Antiperspirant Effect -
 Eliminates Odor
Eliminates Odor -
 PureFoam+ Concentrate
PureFoam+ Concentrate -
97% Natural ingredients
Free Gifts
All Ingredients
Why Flexible Plan?
You'll see best results with 3 months of consistent use. Our flexible plan lets you stay consistent without being locked in. You can pause, skip, or reschedule deliveries anytime, and adjust your plan as your needs change. It’s an easy way to keep your routine on track.
- Never run out
- Enjoy up to a 30% discount
- Consistency is key for better results
- No need to remember to reorder.
- Adjust, pause, or cancel anytime
- Early access to new products
Frequently Bought Together

No Sweat Guarantee
If you’re not completely satisfied within 3 months, we’ll give you a full refund—no strings, no fine print, and no need to return the product to us. It’s truly that simple. Try Calmdry now, 100% risk-free!
How to Use it


PureFoam Concentrate+
-
How does it work?
-
How often should I use it?
-
Suitable for sensitive skin?
-
How does it work?
-
How often should I use it?
-
Suitable for sensitive skin?
Proven Benefits,
Proven Results
*Based on a consumer perception study of 39 people, completing 12 applications of our DeepWash over 28 days.
What to expect?
Popular Products
Frequently Asked Questions
Cancel with ease
Cancel with ease
Need to take a break from your subscription?
For more details of our subscription cancelation policy, or how our customer account works, check out our FAQ here.